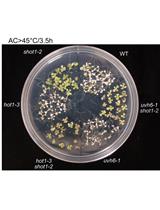
Assessing Plant Tolerance to Acute Heat Stress

- Protocols
- Articles and Issues
- About
- Become a Reviewer
Past Issue in 2017
Volume: 7, Issue: 14
Biochemistry
Cell Type-specific Metabolic Labeling of Proteins with Azidonorleucine in Drosophila
Mass Spectrometry-based in vitro Assay to Identify Drugs that Influence Cystine Solubility
In vitro AMPylation Assays Using Purified, Recombinant Proteins
[2-3H]Mannose-labeling and Analysis of N-linked Oligosaccharides
Cancer Biology
Measurement of the Intracellular Calcium Concentration with Fura-2 AM Using a Fluorescence Plate Reader
Non-radioactive LATS in vitro Kinase Assay
Glioma Induction by Intracerebral Retrovirus Injection
Immunology
Analyzing the Properties of Murine Intestinal Mucins by Electrophoresis and Histology
Preparation of Mosquito Salivary Gland Extract and Intradermal Inoculation of Mice
Microbiology
Using CRISPR/Cas9 for Large Fragment Deletions in Saccharomyces cerevisiae
Quantification of Chlorophyll as a Proxy for Biofilm Formation in the Cyanobacterium Synechococcus elongatus
Bioelectrospray Methodology for Dissection of the Host-pathogen Interaction in Human Tuberculosis
Xanthoferrin Siderophore Estimation from the Cell-free Culture Supernatants of Different Xanthomonas Strains by HPLC
Quantitative Determination of Poly-β-hydroxybutyrate in Synechocystis sp. PCC 6803
Plasmodium Sporozoite Motility on Flat Substrates
Mapping RNA Sequences that Contact Viral Capsid Proteins in Virions
Determination of Survival of Wildtype and Mutant Escherichia coli in Soil
Gene Dosage Experiments in Enterobacteriaceae Using Arabinose-regulated Promoters
The Sulfur Oxygenase Reductase Activity Assay: Catalyzing a Reaction with Elemental Sulfur as Substrate at High Temperatures
Neuroscience
Aldicarb-induced Paralysis Assay to Determine Defects in Synaptic Transmission in Caenorhabditis elegans
Ciberial Muscle 9 (CM9) Electrophysiological Recordings in Adult Drosophila melanogaster
Isolation and Culturing of Rat Primary Embryonic Basal Forebrain Cholinergic Neurons (BFCNs)
Plant Science
GUS Staining of Guard Cells to Identify Localised Guard Cell Gene Expression
Assessing Plant Tolerance to Acute Heat Stress
Rice Lamina Joint Inclination Assay
Non-invasive Protocol for Kinematic Monitoring of Root Growth under Infrared Light
Separation of Plant 6-Phosphogluconate Dehydrogenase (6PGDH) Isoforms by Non-denaturing Gel Electrophoresis
Isolation of Fucus serratus Gametes and Cultivation of the Zygotes
Isolation of Ustilago bromivora Strains from Infected Spikelets through Spore Recovery and Germination
Stem Cell
Implantation of Human Peripheral Corneal Spheres into Cadaveric Human Corneal Tissue










![[2-3H]Mannose-labeling and Analysis of N-linked Oligosaccharides](https://en-cdn.bio-protocol.org/imageup/arcimg/20170718074630401.jpg?t=1774003728)